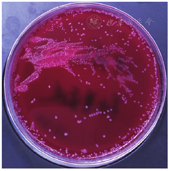

患者,孕妇,35岁,已婚,一胎剖宫产。因"怀孕2次,分娩1次,孕38+4周,待产"入院。神志清,体温为36.5 ℃,血压125/80 mmHg(1 mmHg=0.133 kPa),心率78次/min,律齐,双肺呼吸音清,未及干湿啰音。手术指征:妊娠合并子宫瘢痕,拟行子宫下段剖宫产术终止妊娠,符合"计划性剖宫产"临床路径。剖宫产术前予以头孢替安1 g静脉滴注预防感染。术后第1天,体温36.4 ℃,其他未见异常;术后第2天早晨查体:神清,体温为36.8 ℃,血常规提示:白细胞和快速C反应蛋白均有升高,考虑感染可能,继续予以头孢替安1.5 g,2次/d,静滴抗感染治疗。
版权归中华医学会所有。
未经授权,不得转载、摘编本刊文章,不得使用本刊的版式设计。
除非特别声明,本刊刊出的所有文章不代表中华医学会和本刊编委会的观点。
患者,孕妇,35岁,已婚,一胎剖宫产。因"怀孕2次,分娩1次,孕38+4周,待产"入院。神志清,体温为36.5 ℃,血压125/80 mmHg(1 mmHg=0.133 kPa),心率78次/min,律齐,双肺呼吸音清,未及干湿啰音。手术指征:妊娠合并子宫瘢痕,拟行子宫下段剖宫产术终止妊娠,符合"计划性剖宫产"临床路径。剖宫产术前予以头孢替安1 g静脉滴注预防感染。术后第1天,体温36.4 ℃,其他未见异常;术后第2天早晨查体:神清,体温为36.8 ℃,血常规提示:白细胞和快速C反应蛋白均有升高,考虑感染可能,继续予以头孢替安1.5 g,2次/d,静滴抗感染治疗。
术后第2天下午,患者体温升高,最高达38.1 ℃,考虑乳汁堆积可能,嘱及时排空乳汁,予一般物理降温。立即检查血常规、快速C反应蛋白、降钙素原和IL-6,并采集双侧双瓶送检血培养,感染指标均明显升高。检查结果显示,双乳稍胀,辅检示血象偏高,嘱排空乳汁,继续予头孢替安1.5 g,2次/d,抗感染治疗。术后第3天,体温为36.5 ℃,患者当日体温最高37.3 ℃。剖宫产术后第4天,无发热等不适主诉。体温为36.2 ℃,血常规结果显示,各项指标较术后第3天明显下降,产妇无发热等不适,感染得到明显控制(见表1)。

血流感染孕妇入院后的体温及实验室检查指标数据变化
血流感染孕妇入院后的体温及实验室检查指标数据变化
| 时间 | 实验室检查指标 | ||||||
|---|---|---|---|---|---|---|---|
| 白细胞(×109/L) | 中性粒细胞(×109/L) | 中性粒细胞百分比(%) | 快速C反应蛋白(mg/L) | 降钙素原(ng/mL) | IL-6(pg/mL) | 体温(℃) | |
| 术后当天 | 7.75 | 5.70 | 73.6 | 5.13a | - | - | 36.4 |
| 术后第2天早晨 | 11.85a | 9.52a | 80.3a | 124.41a | - | - | 36.8 |
| 术后第2天下午 | 12.99a | 11.05a | 85.1a | 125.15a | 0.116a | 112.7a | 38.1a |
| 第3天 | 11.97a | 9.79a | 81.8a | 121.66a | - | - | 36.5 |
| 术后第4天 | 9.83a | 7.61a | 77.4a | 103.41 | - | - | 36.2 |
注:a:表示超出正常值上限
术后当天查血细胞,其中白细胞、中性粒细胞、中性粒细胞百分比均正常,C反应蛋白增高为5.13 mg/L。术后第2天早晨查体:神清,体温36.8 ℃,血常规示:白细胞11.85×109/L,中性粒细胞计数9.52×109/L,中性粒细胞百分比80.3%,快速C反应蛋白124.41 mg/L,均增高。术后第2天下午体温升高,急查血常规、快速C反应蛋白、降钙素原、IL-6,并送检血培养。结果显示白细胞12.99×109/L,中性粒细胞百分比85.1%,IL-6 112.7 pg/mL,降钙素原0.116 ng/mL,快速C反应蛋白125.15 mg/L,均明显升高;术后第3天白细胞11.97×109/L,中性粒细胞百分比81.8%,中性粒细胞计数9.79×109/L,快速C反应蛋白121.66 mg/L。
血培养66 h后,双侧厌氧瓶均报告阳性,查看血培养生长曲线,提示为厌氧血培养阳性。需氧血培养瓶培养5 d未报告阴性。抽取血培养厌氧瓶内培养物进行涂片革兰染色,镜检示大量革兰阴性菌(见图1),电话报告危急值一级。从报阳的血培养瓶中用注射器抽取4 mL培养物转入5 mL分离凝胶管,1 600×g离心10 min。弃上清,加入1 mL生理盐水轻轻重悬沉淀。用移液器将重悬液转入1.5 mL离心管中,12 000×g离心2 min,弃去上层的液体后,再次使用1 mL生理盐水重复洗涤1次,12 000×g离心2 min后弃上清。向沉淀物加入10 μL甲酸后混匀,取1 μL进行质谱分析,点样3孔重复。血培养快速质谱仪鉴定结果为羊水普雷沃菌(Prevotella amnii)。


培养物接种血平板、麦康凯和巧克力平板放入厌氧袋培养,24 h后菌落较小形态不明显。继续培养48 h后,菌落为圆形凸起、不透明、灰白色菌落见图2,需氧环境培养未生长。涂片镜检,镜下为革兰阴性短杆菌。头孢硝噻吩纸片法测试结果为阳性,提示临床该菌对β-内酰胺类药物(如青霉素类和头孢菌素类)可能有一定的耐药性。经过48 h厌氧培养,对纯培养菌再次使用质谱进行鉴定,结果与快速质谱鉴定结果一致。挑取纯培养菌落使用煮沸法制备细菌的基因组DNA,使用16S RNA通用引物进行扩增,将扩增产物送上海赛音生物工程有限公司进行测序。测序结果在NCBI网站进行BLAST序列比对分析,鉴定结果为羊水普雷沃菌(NR_042587.1)。


普雷沃菌属(Prevotella)是专性厌氧的革兰阴性杆菌[1],是从拟杆菌属(Bacteroides)中分出来的一个新菌属,可分为不产色素和产色素两大类[2]。该菌属为专性厌氧菌,是人体正常菌群的一部分,多为条件致病菌,常定植于人体口腔、阴道、胃肠道等部位[3]。目前已经有50多个种和1个亚种[4],当机体处于因外伤、手术、免疫状态抑制等情况下,可形成内源性感染。目前已报道的由普雷沃菌属引起感染的菌种主要有中间普雷沃菌、产黑色素普雷沃菌、口腔普雷沃菌、二路普雷沃菌和栖牙普雷沃菌等[5,6,7]。羊水普雷沃菌偶有报道可引起脊髓硬膜外脓肿的感染[8],引起血流感染的病例尚未见报道。
本例患者因剖宫产术后白细胞、中性粒细胞、中性粒细胞百分比出现显著增高,同时C反应蛋白和IL-6等感染指标一直处于较高水平,且术后第2天出现发热症状,临床严格按照血培养采血指征规范采集双侧双瓶血培养送。经过2 d的培养,双侧厌氧血培养瓶均检出羊水普雷沃菌。针对此类特殊厌氧菌群,目前常规实验室采取的手段主要为厌氧袋培养联合生化鉴定卡进行鉴定。但是,由于厌氧菌自身生长缓慢,以及此类菌群感染常合并多重感染的可能等因素限制,导致实验室出具检测结果时间较长。本例患者诊断过程中,我们利用血培养报阳快速质谱鉴定,在血培养报阳后1 h内提供了可靠的致病菌证据,为临床及时准确地调整治疗方案提供了帮助。经过48 h厌氧培养,质谱鉴定结果与快速质谱鉴定结果一致,同时16S RNA测序分析结果与质谱鉴定结果一致。
目前,由于针对此类少见菌群感染在治疗上未能形成统一标准[9],同时美国临床和实验室标准协会(CLSI)等国际及国内指南对于厌氧菌药物敏感性折点未涉及普雷沃菌等少见厌氧菌种。对于此类菌种的临床用药常采取经验性用药,不同菌种及不同感染部位等用药情况未呈现统一性,例如甲硝唑并予以头孢替安联合用药,对于由口普雷沃菌引起的女性患者生殖道脓肿术后血流感染病例临床效果较好[10]。头孢哌酮/他唑巴坦联合甲硝唑治疗剖宫产术后感染有效[11],头孢曲松钠联合甲硝唑对于普雷沃菌致中心静脉导管相关性血流感染有很好的临床疗效[12]。温海楠等[13]建议,针对普雷沃菌属β-内酰胺酶阳性菌株可首选氨苄西林/舒巴坦或阿莫西林/克拉维酸、哌拉西林/他唑巴坦或替卡西林/克拉维酸(当细菌对氨苄西林/舒巴坦或阿莫西林/克拉维酸耐药时选用)、头孢西丁或头孢替坦、亚胺培南或美洛培南、甲硝唑,而对于普雷沃菌属β-内酰胺酶阴性菌株可首选氨苄西林或青霉素、克林霉素、甲硝唑。本案例中患者剖宫产术前已采用头孢替安1 g静脉滴注预防感染,术后仍然感染羊水普雷沃菌,说明低剂量的头孢替安对于此类厌氧菌未能达到预防感染的目标。而术后采用加大药量至头孢替安1.5 g 2次/d进行后续抗感染治疗,体温下降、感染指标降低,一方面为药物因素,另一方面也可能与患者术后自身免疫能力逐步恢复有关。由此可见,针对厌氧菌的感染,由于其生长环境要求的特殊性,实验室的培养与鉴定能力对于临床及时确诊并合理调整用药至关重要。
所有作者均声明不存在利益冲突